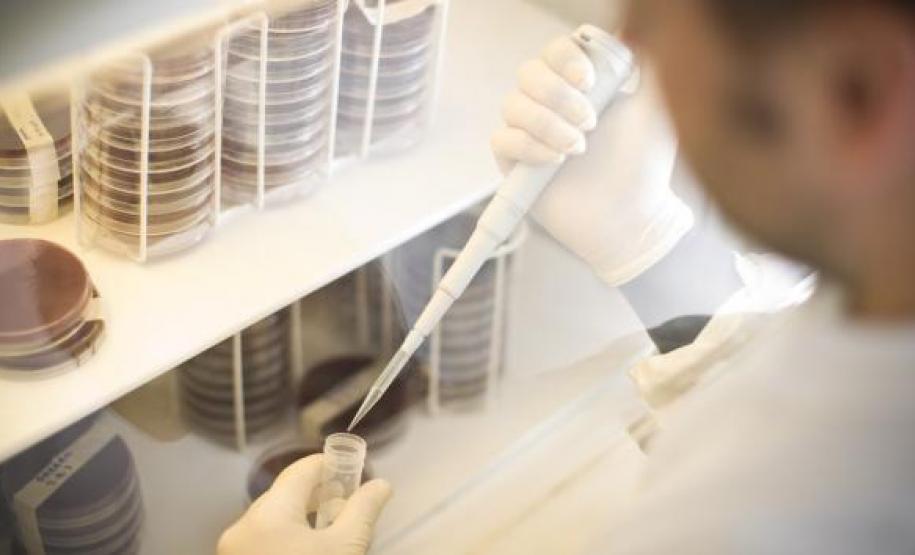
Links

Confap e British Council lançam chamadas para Researcher Links e Institutional Links 15/05/2017 - 13:30
O Conselho Nacional das Fundações Estaduais de Amparo à Pesquisa (Confap), no conjunto de suas Fundações, e o British Council estão com duas Chamadas Públicas abertas para a realização de atividades, dentro do escopo de trabalho do Fundo Newton: a Chamada Pública Researcher Links Workshops Confap – edital 2017-18 e a Chamada Pública Institutional Links Inovação Social – Desenvolvimento Rural e Biodiversidade. Ambas aceitam o envio de propostas até o dia 13 de junho de 2017.
O programa Researcher Links tem como objetivo apoiar a realização de workshops científicos que sirvam como plataformas para a colaboração entre cientistas brasileiros e britânicos. Estes workshops são coordenados por pesquisadores seniores de reconhecida competência nos seus campos de atividades. Os dois coordenadores (um pesquisador britânico e um brasileiro) poderão identificar quatro outros pesquisadores líderes, dois de cada país, para participar como mentores, e os demais participantes deverão ser pesquisadores em início de carreira de ambos os países (entre 12 a 17 de cada país). Os workshops deverão ser em inglês e com duração de três a cinco dias.
A proposta deve trazer um benefício social para o Brasil, ou seja, demonstrar impacto direto ou indireto em populações vulneráveis ou de baixa renda. Todos os projetos financiados pelo Fundo Newton seguem os critérios da OECD para investimento tipo ODA (sigla em inglês para Assistência Internacional para o Desenvolvimento).
O valor disponível para o financiamento de cada workshop é de até 43 mil libras esterlinas. O edital (em inglês) e o formulário de inscrição para esta chamada estão disponíveis no site global do British Council (em inglês). A chamada permanecerá aberta até às dez horas da manhã, do horário de Brasília, do dia 13 de junho de 2017. Os workshops selecionados deverão ser realizados até 31 de agosto de 2018.
Estados – Participam desta Chamada, por meio de suas Fundações, os Estado de Alagoas (Fapeal), Distrito Federal (FAPDF), Espírito Santo (Fapes), Goiás (Fapeg), Maranhão (Fapema), Mato Grosso do Sul (Fundect), Minas Gerais (Fapemig), Pará (Fapespa), Paraíba (Fapesq), Paraná (Fundação Araucária), Pernambuco (Facepe), Santa Catarina (Fapesc) e São Paulo (Fapesp).
Temas – Os workshops devem abordar um dos seguintes temas:
• Agricultura – especialmente voltada à pequena propriedade;
• Clima e meio ambiente (mudança climática, tecnologia verde, desenvolvimento sustentável, serviços de ecossistema, escassez de recursos);
• Energia renovável e energia limpa;
• Educação;
• Crescimento econômico inclusivo;
• Saúde (doenças negligenciadas);
• Água e saneamento;
• Alimentação e nutrição (incluindo segurança alimentar);
• Mudança demográfica/migração/urbanização (foco em urbanização e direitos humanos e transformação urbana);
• Infraestrutura (infraestrutura para desenvolvimento – foco em comunidades remotas);
• Desastres humanitários e emergências;
• Governança, sociedade e conflito (transparência, accountability, instituições eficientes, direito à terra e recursos naturais com foco em populações indígenas, justiça criminal, diminuição da pobreza, desenvolvimento social, desigualdades estruturais, processos de pacificação [peace building] e sociedade civil);
• Coleta, análise de qualidade e acesso a dados relevantes aos índices de desenvolvimento (incluindo informações administrativas e estatísticas macroeconômicas);
• Zika vírus.
Parceiro britânico – A University UK (UUKi), instituição parceira, auxilia as organizações brasileiras a encontrar instituições com interesses similares no Reino Unido para projetos do British Council financiados pelo Fundo Newton. Para saber mais, escreva para newton@international.ac.uk, indicando o assunto “Researcher Links 2017/2018 – Brazil call”.
O Institutional Links, operacionalizado pelo British Council, aceita propostas para um conjunto de atividades de cooperação entre instituições brasileiras e britânicas incluindo workshops, missões, palestras e outras atividades de intercâmbio visando a criação de capacidade instalada no Brasil, que poderão ser realizadas por um período de um ano e meio, até dois anos. O programa é destinado a estabelecer conexões além do nível individual do pesquisador e do agente de inovação, expandindo oportunidades para colaborações mais sustentáveis e orientadas à solução de problemas entre grupos acadêmicos, setor privado e terceiro setor (ONGs, pequenas e médias empresas, centros de transferência de tecnologia e outras organizações sem fins lucrativos).
A chamada visa incentivar parcerias entre instituições localizadas nos estados elegíveis e instituições britânicas de ensino superior e pesquisa, dentro de inovação social, nas áreas de Desenvolvimento Rural e Biodiversidade, a ser abordado de forma interdisciplinar, envolvendo pesquisa aplicada e tendo como foco central o desenvolvimento de capacidades de alcance direto a atores relevantes das áreas contempladas. Esta chamada irá financiar propostas com orçamento mínimo de cem mil libras esterlinas e, no máximo, de cento e quarenta mil libras esterlinas. As propostas devem ter duração entre 18 e 24 meses e compreender os temas elegíveis dos respectivos estados, descritas no item Orientações Temáticas.
A Chamada será encerrada em 13 de junho de 2017. A avaliação das propostas será realizada por meio do Comitê Científico Independente, no Reino Unido e pelos parceiros no Brasil. O resultado será divulgado no site do British Council Brasil em meados de Setembro de 2017.
Cada proposta deve ter um proponente brasileiro e outro proponente do Reino Unido, e ser submetida conjuntamente no site global do British Council. Ambas as instituições, brasileira e britânica, devem ter capacidade de administrar a concessão. Instituições selecionadas poderão incluir instituições parceiras (sem fins lucrativos) associadas para a execução do projeto. Pesquisadores líderes são encorajados a incluir em suas propostas parceiros associados afiliados a outros estabelecimentos de pesquisa ou ensino superior e centros de transferência de tecnologia (technology transfer offices). Os proponentes britânicos devem ser pesquisadores seniores de instituições de ensino superior ou organizações de pesquisa sem fins lucrativos ou Catapult Centres, demonstrando também a relevância de seu trabalho nos temas do escopo desta chamada. Serão consideradas evidências de relevância: títulos, publicações, colaborações internacionais, orientação, experiência/vivência.
Estados – É importante que o pesquisador observe os critérios de elegibilidade exigidos na FAP correspondente ao seu Estado. Participam desta chamada as Fundações de Distrito Federal (FAPDF), Maranhão (Fapema), Minas Gerais (Fapemig), Mato Grosso do Sul (Fundect), Pará (Fapespa), Sergipe (Fapitec), Goiás (Fapeg), Paraná (Fundação Araucária), Alagoas (Fapeal), Santa Catarina (Fapesc) e São Paulo (Fapesp).
Parceiro britânico – A Univesities UK ( UUKi) ajuda organizações brasileiras a encontrar instituições com interesses similares no Reino Unido para projetos do British Council financiados pelo Fundo Newton. Para encontrar um parceiro britânico, o interessado precisa preencher o formulário (em inglês) e seu anúncio ficará disponível para a comunidade acadêmica do Reino Unido. Em caso de dúvidas, escreva para newton@international.ac.uk indicando o assunto “Institutional Links 2017/2018 – Brazil April call”.
Para dúvidas em relação ao formulário e à chamada global, entre em contato (em inglês) pelo email newton@international.ac.uk. Em caso de dúvidas quanto à elegibilidade de sua organização, entre em contato pelo e-mail: newton@britishcouncil.org.br.
Link do formulário: http://www.universitiesuk.ac.uk/International/funding-and-opportunities/newton/Pages/finding-a-collaborator-form.aspx
Site do British Council: https://www.britishcouncil.org/education/science/current-opportunities/newton-institutional-links-april-2017?_ga=1.11879924.152891422.1491511234
Institucional Links: https://www.britishcouncil.org.br/newton-fund/chamadas/institutional-links-desenvolvimento-rural-biodiversidade-2017
Researcher Links: https://www.britishcouncil.org.br/newton-fund/chamadas/researcher-links-confap-2017-2018
Fonte: Coordenadoria de Comunicação do Confap, com informações do British Council.